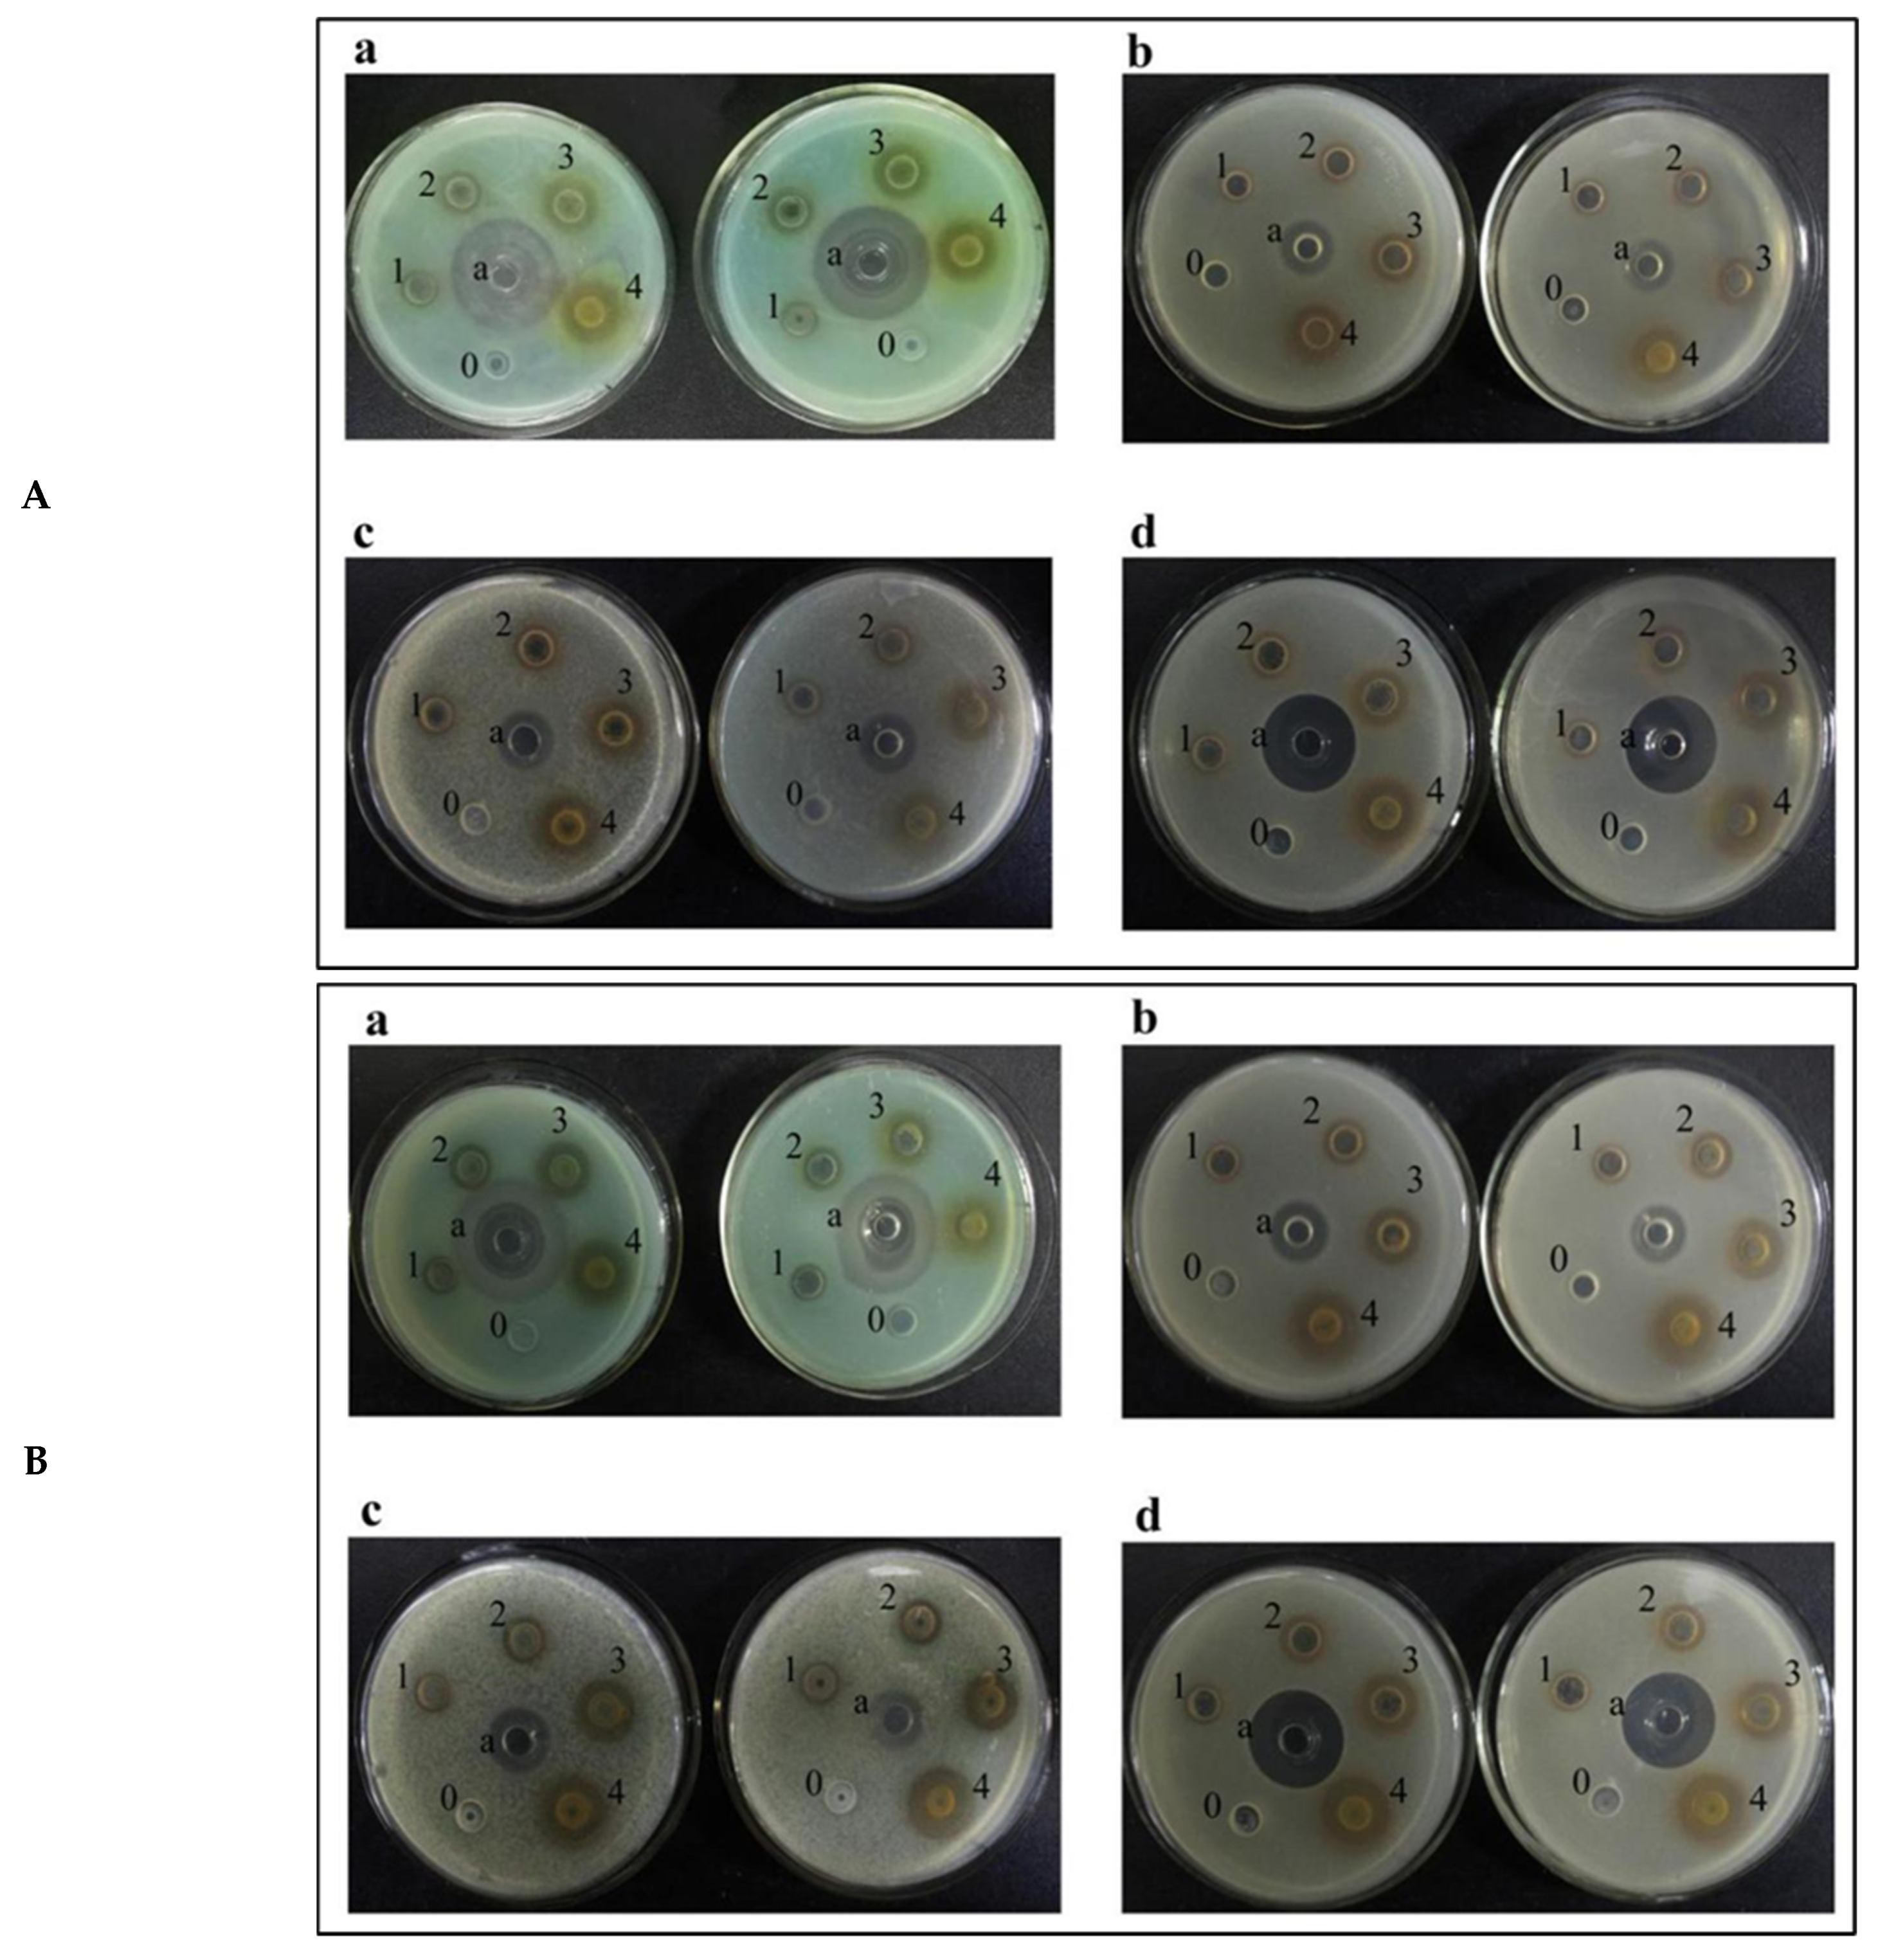

Antioxidant, Bacteriostatic and Preservative Effects of Extractable Condensed Tannins Isolated from Longan Pericarps and Seeds
Abstract
1. Introduction
2. Results and Discussion
2.1. Total Phenolics and Extractable Condensed Tannins of Longan Pericarps and Seeds
2.2. Antioxidant Activity of Longan Pericarps and Seeds
2.3. Analysis of Bacteriostatic Ability
2.3.1. Analysis of Inhibition Ability to Common Bacteria
2.3.2. Total Bacterial Count of Fresh-Cut Lotus Roots
2.4. Preservation Effect on Fresh-Cut Lotus Roots
2.4.1. Apparent Changes in Fresh-Cut Lotus Roots
2.4.2. Browning Degree of Fresh-Cut Lotus Roots
2.4.3. Total Phenolic and Soluble Quinone Contents in Fresh-Cut Lotus Roots
2.4.4. Weight Loss Rate of Fresh-Cut Lotus Roots
2.4.5. Malondialdehyde Content in Fresh-Cut Lotus Roots
3. Materials and Methods
3.1. Experimental Materials
3.2. Extraction of ECTs
3.3. Determination of Total Phenolic Content
3.4. Determination of ECT Content
3.5. Antioxidant Capacity of ECTs
3.5.1. DPPH Method
3.5.2. FRAP Method
3.6. Antibacterial Activity of ECTs
3.6.1. Bacterial Culture
3.6.2. Bacteriostatic Activity
3.6.3. Total Colony Count
3.7. Effects of ECTs on Preservation of Fresh-Cut Lotus Roots
3.7.1. Apparent Changes in Lotus Roots
3.7.2. Color Change and Browning Index
3.7.3. Total Phenolic and Soluble Quinone Contents
3.7.4. Determination of Weight Loss Rate
3.7.5. Malondialdehyde Content
3.8. Statistical Analysis
4. Conclusions
Author Contributions
Funding
Institutional Review Board Statement
Informed Consent Statement
Data Availability Statement
Acknowledgments
Conflicts of Interest
Abbreviations
References
- Xiao, G.H.; Huang, R.Q.; Zeng, Q.X.; Chen, W.D.; Liu, X.M.; Rui, H.M. Nutrition composition of Longan seeds. Food Sci. Technol. 2004, 01, 93–94. [Google Scholar]
- Cai, C.H.; Tang, X.L.; Zhang, A.Y.; Shu, Z.S.; Xiao, W.Q.; Li, W.Y. The therapeutic value of longan meat and its development and utilization prospects. Food Sci. Technol. 2002, 23, 328–330. [Google Scholar]
- Pan, Y.; Huang, S.; Wang, H.; Shen, Z.; Liang, M.; Huang, Z. Free Radical Scavenging Activities of Extracts from Peel of Dimocarpus Longan by Different Methods. Fine Chem. 2006, 23, 568–570. [Google Scholar]
- Zhang, L.L.; Wang, Y.M.; Xu, M.; Wu, D.M.; Chen, J.H. Research Progress in Analytical Methods of Vegetable Tannins. Chem. Ind. For. Prod. 2012, 32, 107–116. [Google Scholar]
- Soong, Y.Y.; Barlow, P.J. Antioxidant activity and phenolic content of selected fruit seeds. Food Chem. 2004, 88, 411–417. [Google Scholar] [CrossRef]
- Zheng, W.; Wang, S.Y. Antioxidant activity and phenolic compounds in selected herbs. J. Agric. Food Chem. 2001, 49, 5165–5170. [Google Scholar] [CrossRef]
- Ruberto, G.; Renda, A.; Daquino, C.; Amico, V.; Spatafora, C.; Tringali, C.; Tommasi, N. Polyphenol constituents and antioxidant activity of grape pomace extracts from five Sicilian red grape cultivars. Food Chem. 2007, 100, 203–210. [Google Scholar] [CrossRef]
- Prasad, K.N.; Bao, Y.; Yang, S.; Chen, Y.; Zhao, M.; Ashraf, M.; Jiang, Y. Identification of phenolic compounds and appraisal of antioxidant and antityrosinase activities from litchi (Litchi sinensis Sonn.) seeds. Food Chem. 2009, 116, 1–7. [Google Scholar] [CrossRef]
- Prasad, K.N.; Yang, B.; Shi, J.; Yu, C.; Zhao, M.; Xue, S.; Jiang, Y. Enhanced antioxidant and antityrosinase activities of longan fruit pericarp by ultra-high-pressure-assisted extraction. J. Pharm. Biomed. Anal. 2010, 51, 471–477. [Google Scholar] [CrossRef]
- Reddy, M.K.; Gupta, S.K.; Jacob, M.R.; Khan, S.I.; Daneel, F. Antioxidant, antimalarial and antimicrobial activities of tannin-rich fractions, ellagitannins and phenolic acids from Punica granatum L. Planta Med. 2007, 73, 461–467. [Google Scholar] [CrossRef]
- Sudjaroen, Y.; Hull, W.E.; Erben, G.; Würtele, G.; Changbumrung, S.; Ulrich, C.M.; Owen, R.W. Isolation and characterization of ellagitannins as the major polyphenolic components of Longan (Dimocarpus longan Lour) seeds. Phytochemistry 2012, 77, 226–237. [Google Scholar] [CrossRef] [PubMed]
- Wang, Z.; Gao, X.; Li, W.; Tan, S.; Zheng, Q. Phenolic content, antioxidant capacity, and α-amylase and α-glucosidase inhibitory activities of Dimocarpus longan Lour. Food Sci. Biotechnol. 2020, 29, 683–692. [Google Scholar] [CrossRef] [PubMed]
- He, T.; Wang, K.; Zhao, L.; Chen, Y.; Zhou, W.; Liu, F.; Hu, Z. Interaction with longan seed polyphenols affects the structure and digestion properties of maize starch. Carbohydr. Polym. 2021, 256, 117537. [Google Scholar] [CrossRef] [PubMed]
- Lin, Y.; Min, J.; Lai, R.; Wu, Z.; Chen, Y.; Yu, L.; Cheng, C.; Jin, Y.; Tian, Q.; Liu, Q.; et al. Genome-wide sequencing of longan (Dimocarpus longan Lour.) provides insights into molecular basis of its polyphenol-rich characteristics. Gigascience 2017, 6, 1–14. [Google Scholar] [CrossRef]
- Ghidelli, C.; Pérez-Gago, M.B. Recent advances in modified atmosphere packaging and edible coatings to maintain quality of fresh-cut fruits and vegetables. Crit. Rev. Food Sci. Nutr. 2018, 58, 662–679. [Google Scholar] [CrossRef] [PubMed]
- Ansah, F.A.; Amodio, M.L.; Colelli, G. Quality of fresh-cut products as affected by harvest and postharvest operations. J. Sci. Food Agric. 2018, 98, 3614–3626. [Google Scholar] [CrossRef] [PubMed]
- Olivas, G.I.; Barbosa-Cánovas, G.V. Edible coatings for fresh-cut fruits. Crit. Rev. Food Sci. Nutr. 2005, 45, 657–670. [Google Scholar] [CrossRef]
- Mahajan, P.V.; Luca, A.; Edelenbos, M. Impact of mixtures of different fresh-cut fruits on respiration and ethylene production rates. J. Food Sci. 2014, 79, E1366–E1371. [Google Scholar] [CrossRef]
- Dhall, R.K. Advances in edible coatings for fresh fruits and vegetables: A review. Crit. Rev. Food Sci. Nutr. 2013, 53, 435–450. [Google Scholar] [CrossRef]
- Agriopoulou, S.; Stamatelopoulou, E.; Sachadyn-Król, M.; Varzakas, T. Lactic Acid Bacteria as Antibacterial Agents to Extend the Shelf Life of Fresh and Minimally Processed Fruits and Vegetables: Quality and Safety Aspects. Microorganisms 2020, 8, 952. [Google Scholar] [CrossRef]
- Soong, Y.Y.; Barlow, P.J. Isolation and structure elucidation of phenolic compounds from longan (Dimocarpus longan Lour.) seed by high-performance liquid chromatography-electrospray ionization mass spectrometry. J. Chromatogr. A 2005, 1085, 270–277. [Google Scholar] [CrossRef] [PubMed]
- Chandra, H.; Bishnoi, P.; Yadav, A.; Patni, B.; Mishra, A.P.; Nautiyal, A.R. Antimicrobial Resistance and the Alternative Resources with Special Emphasis on Plant-Based Antimicrobials—A Review. Plants 2017, 6, 16. [Google Scholar] [CrossRef] [PubMed]
- Jones, S.B., Jr.; Luchsinger, A.E. Plant Systematics; McGraw-Hill: New York, NY, USA, 1986. [Google Scholar]
- Rangkadilok, N.; Tongchusak, S.; Boonhok, R.; Chaiyaroj, S.C.; Junyaprasert, V.B.; Buajeeb, W.; Akanimanee, J.; Raksasuk, T.; Suddhasthira, T.; Satayavivad, J. In vitro antifungal activities of longan (Dimocarpus longan Lour.) seed extract. Fitoterapia 2012, 83, 545–553. [Google Scholar] [CrossRef] [PubMed]
- Ayala-Zavala, J.F.; Oms-Oliu, G.; Odriozola-Serrano, I.; González-Aguilar, G.A.; Álvarez-Parrilla, E.; Martín-Belloso, O. Bio-preservation of fresh-cut tomatoes using natural antimicrobials. Eur. Food Res. Technol. 2008, 226, 1047–1055. [Google Scholar] [CrossRef]
- Do-Hee, K.; Han-Bit, K.; Hun-Sik, C.; Kwang-Deog, M. Browning control of fresh-cut lettuce by phytoncide treatment. Food Chem. 2014, 159, 188–192. [Google Scholar]
- Xing, R.; Zheng, A.; Wang, F.; Wang, L.; Yu, Y.; Jiang, A. Functionality study of Na6PMo11FeO40 as a mushroom tyrosinase inhibitor. Food Chem. 2015, 175, 292–299. [Google Scholar] [CrossRef]
- Scalbert, A.; Williamson, G. Dietary intake and bioavailability of polyphenols. J. Nutr. 2000, 130, 2073S. [Google Scholar] [CrossRef]
- Bajwa, V.S.; Shukla, M.R.; Sherif, S.M.; Murch, S.J.; Saxena, P.K. Identification and characterization of serotonin as an anti-browning compound of apple and pear. Postharvest Biol. Technol. 2015, 110, 183–189. [Google Scholar] [CrossRef]
- Chai, W.M.; Shi, Y.; Feng, H.L.; Qiu, L.; Zhou, H.C.; Deng, Z.W.; Yan, C.L.; Chen, Q.X. NMR, HPLC-ESI-MS, and MALDI-TOF MS analysis of condensed tannins from Delonix regia (Bojer ex Hook.) Raf. and their bioactivities. J. Agric. Food Chem. 2012, 60, 5013–5022. [Google Scholar] [CrossRef]
- Arya, S.S.; Rookes, J.E.; Cahill, D.M.; Lenka, S.K. Chitosan nanoparticles and their combination with methyl jasmonate for the elicitation of phenolics and flavonoids in plant cell suspension cultures. Int. J. Biol. Macromol. 2022, 214, 632–641. [Google Scholar] [CrossRef]
- Terrill, T.H.; Rowan, A.M.; Douglas, G.B.; Barry, T.N. Determination of extractable and bound condensed tannin concentrations in forage plants, protein concentrate meals and cereal grains. J. Sci. Food Agric. 2010, 58, 321–329. [Google Scholar] [CrossRef]
- Lin, Y.M.; Liu, J.W.; Xiang, P.; Lin, P.; Ye, G.F.; Sternberg, L.S.L.D. Tannin Dynamics of Propagules and Leaves of Kandelia candel and Bruguiera gymnorrhiza in the Jiulong River Estuary, Fujian, China. Biogeochemistry 2006, 78, 343–359. [Google Scholar] [CrossRef]
- Arya, S.; Sonawane, H.; Math, S.; Tambade, P.; Chaskar, M.; Shinde, D. Biogenic titanium nanoparticles (TiO2NPs) from Tricoderma citrinoviride extract: Synthesis, characterization and antibacterial activity against extremely drug-resistant Pseudomonas aeruginosa. Int. Nano Lett. 2021, 11, 35–42. [Google Scholar] [CrossRef]
- Benzie, I.F.; Strain, J.J. The ferric reducing ability of plasma (FRAP) as a measure of “antioxidant power”: The FRAP assay. Anal. Biochem. 1996, 239, 70–76. [Google Scholar] [CrossRef] [PubMed]
- Dongmei, L.; Li, L.; Xiaoquan, Y.; Shizhong, L. Determination of the antimicrobial activity of probiotic by oxford plate assay system. Food Res. Dev. 2006, 3, 110–111. [Google Scholar]
- Zheng, W.W.; Chun, I.J.; Hong, S.B.; Zang, Y.X. Quality characteristics of fresh-cut ‘Fuji’ apple slices from 1-methylcyclopropene-, calcium chloride-, and rare earth-treated intact fruits. Sci. Hortic. 2014, 173, 100–105. [Google Scholar] [CrossRef]
- Shao, L.L.; Wang, X.L.; Chen, K.; Dong, X.W.; Kong, L.M.; Zhao, D.Y.; Hider, R.C.; Zhou, T. Novel hydroxypyridinone derivatives containing an oxime ether moiety: Synthesis, inhibition on mushroom tyrosinase and application in anti-browning of fresh-cut apples. Food Chem. 2018, 242, 174–181. [Google Scholar] [CrossRef]
- Gao, H.; Chai, H.K.; Cheng, N.; Cao, W. Effects of 24-epibrassinolide on enzymatic browning and antioxidant activity of fresh-cut lotus root slices. Food Chem. 2017, 217, 45–51. [Google Scholar] [CrossRef]
- Hinneburg, I.; Dorman, H.J.D.; Hiltunen, R. Antioxidant activities of extracts from selected culinary herbs and spices. Food Chem. 2006, 97, 122–129. [Google Scholar] [CrossRef]
- Banerjee, A.; Penna, S.; Variyar, P.S. Allyl isothiocyanate enhances shelf life of minimally processed shredded cabbage. Food Chem. 2015, 183, 265–272. [Google Scholar] [CrossRef]
- Dhindsa, R.S.; Plumbdhindsa, P.; Thorpe, T.A. Leaf Senescence: Correlated with Increased Levels of Membrane Permeability and Lipid Peroxidation, and Decreased Levels of Superoxide Dismutase and Catalase. J. Exp. Bot. 1981, 32, 93–101. [Google Scholar] [CrossRef]

| Samples | Total Phenolics (mg/g) | Extractable Condensed Tannins (mg/g) |
|---|---|---|
| Fresh longan pericarp (FLP) | 57.48 ± 2.81 | 33.52 ± 5.23 |
| Fresh longan seed (FLS) | 78.82 ± 1.35 | 56.67 ± 3.29 |
| Dried longan pericarp (DLP) | 39.58 ± 3.54 | 19.25 ± 6.71 |
| Dried longan seed (DLS) | 69.53 ± 1.99 | 44.59 ± 2.05 |
| DPPH (IC50 μg/mL) | FRAP (mg AAE/mg) | |
|---|---|---|
| Fresh longan pericarp | 215.67 ± 1.24 | 0.47 ± 0.20 |
| Fresh longan seed | 167.11 ± 2.59 | 0.64 ± 0.29 |
| Dried longan pericarp | 264.80 ± 5.45 | 0.34 ± 0.10 |
| Dried longan seed | 198.42 ± 3.76 | 0.62 ± 0.31 |
| Vitamin C | 112.80 ± 1.65 | 1 |
| Concentration of ECTs (mg/mL) | ||||||||||
|---|---|---|---|---|---|---|---|---|---|---|
| Strain | 6 | 3 | 1.5 | 0.75 | 0.3625 | |||||
| A | B | A | B | A | B | A | B | A | B | |
| a | 1.1 | 1.13 | 0.93 | 1.05 | / | 0.9 | / | / | / | / |
| b | 1.03 | 1.08 | 0.95 | 0.98 | / | 0.95 | / | / | / | / |
| c | 1.03 | 1.13 | 0.95 | 1.05 | / | / | / | / | / | / |
| d | 1.05 | 1.18 | 0.98 | 1.02 | / | 0.9 | / | / | / | / |
Disclaimer/Publisher’s Note: The statements, opinions and data contained in all publications are solely those of the individual author(s) and contributor(s) and not of MDPI and/or the editor(s). MDPI and/or the editor(s) disclaim responsibility for any injury to people or property resulting from any ideas, methods, instructions or products referred to in the content. |
© 2023 by the authors. Licensee MDPI, Basel, Switzerland. This article is an open access article distributed under the terms and conditions of the Creative Commons Attribution (CC BY) license (https://creativecommons.org/licenses/by/4.0/).
Share and Cite
Wang, M.; Chen, T.; Wang, Q.; Shi, Y. Antioxidant, Bacteriostatic and Preservative Effects of Extractable Condensed Tannins Isolated from Longan Pericarps and Seeds. Plants 2023, 12, 512. https://doi.org/10.3390/plants12030512
Wang M, Chen T, Wang Q, Shi Y. Antioxidant, Bacteriostatic and Preservative Effects of Extractable Condensed Tannins Isolated from Longan Pericarps and Seeds. Plants. 2023; 12(3):512. https://doi.org/10.3390/plants12030512
Chicago/Turabian StyleWang, Mengli, Ting Chen, Qin Wang, and Yan Shi. 2023. "Antioxidant, Bacteriostatic and Preservative Effects of Extractable Condensed Tannins Isolated from Longan Pericarps and Seeds" Plants 12, no. 3: 512. https://doi.org/10.3390/plants12030512
APA StyleWang, M., Chen, T., Wang, Q., & Shi, Y. (2023). Antioxidant, Bacteriostatic and Preservative Effects of Extractable Condensed Tannins Isolated from Longan Pericarps and Seeds. Plants, 12(3), 512. https://doi.org/10.3390/plants12030512

